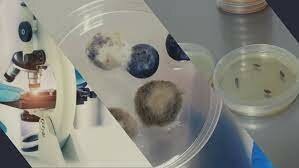
SIGLOS XX Y XXI

-
Hallazgos de cráneos en la época de las cavernas que presentaban orificios, pues se creía que las personas se enfermaban porque eran poseídas por espíritus malvados, y abrir un orificio era una forma de liberarlos.
-
 Las primeras enfermedades infecciosas de plantas - "samana" y "mehru"- fueron registradas por el año 2000 a. C. en los fértiles
Las primeras enfermedades infecciosas de plantas - "samana" y "mehru"- fueron registradas por el año 2000 a. C. en los fértiles
valles de Mesopotamia donde se cultivaban trigo y
cebada, pero más tarde hubo registros de enfermedades similares en la agricultura primitiva india, china y americana. Para proteger los cultivos de cebada de las enfermedades (actual roya de la cebada), rendían culto a diferentes dioses. -
 La antigua India recoge conjuros para alejar las enfermedades de las plantas, pero en contraste, los antiguos cultivadores chinos tenían sus deidades, a menudo de descendencia real, para amparar sus cultivos.
La antigua India recoge conjuros para alejar las enfermedades de las plantas, pero en contraste, los antiguos cultivadores chinos tenían sus deidades, a menudo de descendencia real, para amparar sus cultivos. -
 Los romanos en la era precristiana realizaban ritos que consistían en levantar una especie de barrera viva con terneros, corderos y cerdos alrededor de los lotes sembrados con el fin de proteger los cultivos. Algunas enfermedades en plantas se combatían con orina humana o heces esparcidas alrededor de los árboles, y se creía que las mujeres en menstruación tenían la potestad de matar las plantas con solo verlas, a lo que se le conoce comúnmente como "mal de ojo".
Los romanos en la era precristiana realizaban ritos que consistían en levantar una especie de barrera viva con terneros, corderos y cerdos alrededor de los lotes sembrados con el fin de proteger los cultivos. Algunas enfermedades en plantas se combatían con orina humana o heces esparcidas alrededor de los árboles, y se creía que las mujeres en menstruación tenían la potestad de matar las plantas con solo verlas, a lo que se le conoce comúnmente como "mal de ojo". -
 En la edad media, autoridades eclesiásticas, medicas, empíricos contribuyen y afianzan esta teoría de fuerzas maléficas y premoniciones teniendo en cuenta los acontecimientos ambientales que sucedían, cada evento tenia su significado para marcar el inicio, duración o final de la enfermedad.
En la edad media, autoridades eclesiásticas, medicas, empíricos contribuyen y afianzan esta teoría de fuerzas maléficas y premoniciones teniendo en cuenta los acontecimientos ambientales que sucedían, cada evento tenia su significado para marcar el inicio, duración o final de la enfermedad. -
 La medicina religiosa o sacerdotal, llamada también teoría punitiva, se vale de que las enfermedades son un castigo designados por los dioses, a los hombres por haber cometido crímenes, o no haber
La medicina religiosa o sacerdotal, llamada también teoría punitiva, se vale de que las enfermedades son un castigo designados por los dioses, a los hombres por haber cometido crímenes, o no haber
obedecido a ciertas normas culturales, ambientales o por cualquier otro motivo. El papa pedía clemencia al cielo durante la pandemia medieval de peste negra, puesto que esta enfermedad era por "obra de los cuerpos superiores". -
 La medicina ayurvédica: El universo es combinación de cinco elementos (aire, fuego, espacio agua y tierra)
La medicina ayurvédica: El universo es combinación de cinco elementos (aire, fuego, espacio agua y tierra)
Para Hipócrates y sus adherentes, como Galeno y Avicena, la salud depende de la armonía entre los humores y del equilibrio humoral o eucrasia. -
 Esta teoría nació en la cultura Babilónica. Plantea en esencia que las estrellas y los planetas afectan el comportamiento de las personas y de las plantas. El horóscopo agrícola constituía una especie de guía basada en los ciclos lunares para las fechas de siembra y operaciones mensuales, y así tener unos cultivos sanos y una buena cosecha. Es una teoría que es considerada actualmente.
Esta teoría nació en la cultura Babilónica. Plantea en esencia que las estrellas y los planetas afectan el comportamiento de las personas y de las plantas. El horóscopo agrícola constituía una especie de guía basada en los ciclos lunares para las fechas de siembra y operaciones mensuales, y así tener unos cultivos sanos y una buena cosecha. Es una teoría que es considerada actualmente. -
Friedrich Hoffmann, profesor de Medicina propuso la teoría de la "patología de sólidos", esta teoría preconizó que toda enfermedad es la consecuencia de "la alteración de los impulsos vitales de la circulación", bien por contracción excesiva de las partes sólidas o bien por su distensión.
-
clasificó las enfermedades de las plantas en externas e internas
al igual que en las antiguas ciencias agrícolas india y romana y en la antigua medicina egipcia. Las enfermedades internas de las plantas eran causadas por la bilis y la flema, y las externas por el medio ambiente y los insectos. -
 Realizó investigaciones sobre la muerte de la planta de azafrán, aisló cuerpos globosos (esclerocios o estructuras de resistencia) de un hongo en lesiones de plantas enfermas, es decir, extrajo la causa necesaria, y describió los síntomas tanto en el campo como sobre plantas sanas inoculadas con las estructuras globosas, con lo cual cumplió en parte el requisito de causa suficiente.
Realizó investigaciones sobre la muerte de la planta de azafrán, aisló cuerpos globosos (esclerocios o estructuras de resistencia) de un hongo en lesiones de plantas enfermas, es decir, extrajo la causa necesaria, y describió los síntomas tanto en el campo como sobre plantas sanas inoculadas con las estructuras globosas, con lo cual cumplió en parte el requisito de causa suficiente. -
Consideró cinco categorías de enfermedades de las plantas: flemasias o enfermedades inflamatorias, parálisis o debilidad,
descarga o drenaje, caquexia o mala constitución y defectos o malformaciones de diferentes órganos. -
 Se propone que las exhalaciones pútridas y vapores o gases
Se propone que las exhalaciones pútridas y vapores o gases
liberados por la materia orgánica vegetal o animal en descomposición, eran causantes de enfermedades. Esta teoría respalda literatura fitopatologica antigua, donde se creía que los vapores de los ríos y pantanos y, en general, los vapores nocivos eran una de las causas de las llamadas enfermedades externas, dañaban las plantas, su proceso de floración y reducían su
rendimiento, especialmente en lugares cálidos. -
 Observó al microscopio las esporas del hongo asociado con la caries del trigo, las cuales al ser inoculadas a plántulas sanas, causaron la misma enfermedad, demostrando que un hongo era la causa necesaria y suficiente para que se desarrollara la enfermedad.
Observó al microscopio las esporas del hongo asociado con la caries del trigo, las cuales al ser inoculadas a plántulas sanas, causaron la misma enfermedad, demostrando que un hongo era la causa necesaria y suficiente para que se desarrollara la enfermedad. -
 En 1865 identificó una estructura corpuscular parecida a glóbulos de sangre en los gusanos de seda muertos, es decir observó lo que se puede denominar la causa necesaria para inducir enfermedad y muerte de los gusanos. En 1876 investigó la causa de la infección urinaria en el hombre, y elaboró la estrategia para establecer la conexión suficiente entre microbios y enfermedad.
En 1865 identificó una estructura corpuscular parecida a glóbulos de sangre en los gusanos de seda muertos, es decir observó lo que se puede denominar la causa necesaria para inducir enfermedad y muerte de los gusanos. En 1876 investigó la causa de la infección urinaria en el hombre, y elaboró la estrategia para establecer la conexión suficiente entre microbios y enfermedad. -
 Confirmo la enfermedad del "tizón tardío" o "gota de la papa", la causante de la gran hambruna en Irlanda entre los años 1845-1852. al reproducir en el laboratorio la enfermedad en plantas sanas inoculadas con esporas de un hongo previamente aislado de plantas enfermas, Igualmente, se aplicaron versiones incompletas de los postulados de Koch entre 1845 y 1868 en los primeros estudios etiológicos de enfermedades bacterianas en plantas.
Confirmo la enfermedad del "tizón tardío" o "gota de la papa", la causante de la gran hambruna en Irlanda entre los años 1845-1852. al reproducir en el laboratorio la enfermedad en plantas sanas inoculadas con esporas de un hongo previamente aislado de plantas enfermas, Igualmente, se aplicaron versiones incompletas de los postulados de Koch entre 1845 y 1868 en los primeros estudios etiológicos de enfermedades bacterianas en plantas. -
 Realizó estudios sobre las infecciones de heridas, y en 1882 formuló postulados de Koch, con el fin de establecer la relación de causa a efecto en el estudio etiológico de las enfermedades, con la que se demostró para la tuberculosis, el microorganismo debe estar presente en el hospedero enfermo y ausente en el hospedero sano para que se convierta en causa necesaria.
Realizó estudios sobre las infecciones de heridas, y en 1882 formuló postulados de Koch, con el fin de establecer la relación de causa a efecto en el estudio etiológico de las enfermedades, con la que se demostró para la tuberculosis, el microorganismo debe estar presente en el hospedero enfermo y ausente en el hospedero sano para que se convierta en causa necesaria. -
 En los primeros años del siglo XX, el descubrimiento del carácter mendeliano de la herencia de la resistencia en las royas de
En los primeros años del siglo XX, el descubrimiento del carácter mendeliano de la herencia de la resistencia en las royas de
los cereales estimuló el desarrollo de programas de mejoramiento que permitieron mitigar las pérdidas ocasionadas por esas
enfermedades. Otros hechos relevantes han estado relacionados con el control químico de las enfermedades. El azufre, clásico
remedio de la medicina humana, fue el primer producto utilizado para luchar contra hongos patógenos de plantas. -
El uso de la Biotecnología para la mejora de los métodos de detección de patógenos mediante técnicas moleculares (PCR cuantitativa, NASBA, Micromatrices), el desarrollo de una nueva generación de métodos de control biológico y bioquímico (cepas de agentes de biocontrol más eficientes y mejor formuladas, péptidos antimicrobianos, elicitores de defensa, silenciamiento génico, plantas transgénicas más seguras, etc.).
El uso de la Biotecnología para la mejora de los métodos de detección de patógenos mediante técnicas moleculares (PCR cuantitativa, NASBA, Micromatrices), el desarrollo de una nueva generación de métodos de control biológico y bioquímico (cepas de agentes de biocontrol más eficientes y mejor formuladas, péptidos antimicrobianos, elicitores de defensa, silenciamiento génico, plantas transgénicas más seguras, etc.).
https://sef.es/sites/default/files/publications/SEF18tw.pdf
Looking for a timeline maker?
Create timelines for projects, roadmaps, history, lessons, legal cases, and stories with Timetoast. Timetoast is a timeline maker for work, school, research, and stories.